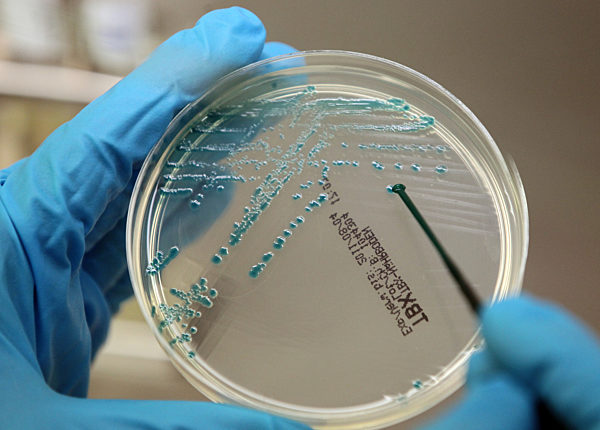
EHEC-Welle breitet sich aus - Labor
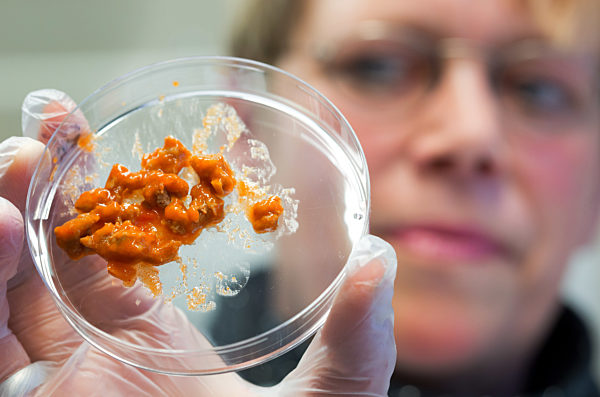
Untersuchungen wegen Pferdefleischskandal

Skandale in Deutschland
Die Knef, der Spiegel, Contergan, Plagiate, Fipronil im Ei und gefälschte Hitler-Tagebücher: Zahlreiche politische Affären und Skandale um Spenden, Lebensmittel und Abgase haben die Bundesrepublik immer wieder in Atem gehalten.

13.11.1962 - Claus Jacobi (r) trifft nach seiner Haftentlassung am 13.November 1962 auf dem Hamburger Hauptbahnhof ein, wo er von "Spiegel"-Mitarbeitern begrüßt wird. Er wurde entlassen, da lau...
2399810

26.03.1984 - General Günter Kießling (l) und Bundesverteidigungsminister Manfred Wörner geben sich nach dem Abschiedsempfang die Hand. Am 26. März 1984 wurde Kießling in der Ernst-Moritz-Arndt-...
2467936

07.08.1978 - Der CDU-Politiker und baden-württembergische Ministerpräsident Dr. Hans Filbinger gibt am 7. August 1978 seinen Rücktritt bekannt und zieht damit die Konsequenzen aus der Kontrover...
2356191

07.08.1978 - Der CDU-Politiker und baden-württembergische Ministerpräsident Dr. Hans Filbinger (r) gibt am 7. August 1978 in Stuttgart seinen Rücktritt bekannt und zieht damit die Konsequenzen...
2356215

09.11.1962 - Verteidigungsminister Franz Josef Strauß (l,CSU) im Gespräch mit Bundeskanzler Konrad Adenauer während der Debatte. Am 9. November 1962 fand die dritte "Spiegel-Debatte" im Deutsch...
2314430

06.06.1971 - Der Präsident der Offenbacher Kickers, Gregorio Canellas (Mitte), und der Tontechniker Werner Hix (ganz rechts) spielen bei einer Pressekonferenz in Offenbach am 6.6.1971 ein Tonba...
1582393

30.11.1961 - Vier Maschinen des Typs Starfighter F 104 F bei einem Formationsflug. Eine Kunstflugstaffel der Bundesluftwaffe bestehend aus vier Maschinen des Typs Starfighter F 104 F sind am 19...
2294813

07.06.1971 - Der Präsident der Offenbacher Kickers, Gregorio Canellas (r), erhebt bei einer Pressekonferenz in Hausen bei Offenbach am 7. Juni 1971 Anspruch auf einen Platz seines Vereins in de...
2089488

10.02.1982 - Der Vorstandsvorsitzende der gewerkschaftseigenen Wohnungsbaugesellschaft Neue Heimat, Albert Vietor, beim Betreten des NH-Hauses in Hamburg am 10. Februar 1982.
2096185

31.07.1985 - Zwei Krefelder Bürger bringen am 31. Juli 1985 Flaschen mit gepanschtem Wein zu einem eigens dafür aufgestellten Container. Nach der Entdeckung von Frostschutzmitteln (Glykol) in R...
2096883

21.08.1984 - Die Angeklagten Konrad Kujau (r) und Gerd Heidemann (l) mit ihren Anwälten Gesine Frömming und Reinhard Daum zu Verhandlungsbeginn am 21. August 1984 vor der großen Strafkammer des...
1980334

31.05.2002 - Magdeburg (Sachsen-Anhalt): Ein Schild der Hühnerhof Heidegold GmbH Fintel (Niedersachsen) macht am 31.05.2002 am Eierstand eines Lebensmittelmarktes bei Karstadt in Magdeburg auf...
3014648

07.05.1990 - Rund 40 Angehörige der Mieterinitiative Neue Heimat protestieren am 7. Mai 1990 vor der bayerischen DGB-Zentrale in München gegen den Verkauf ihrer Wohnungen an den Münchner Bauunt...
1306967

18.04.1969 - Kriminalobermeister Karl-Heinz Kurras (r) mit seinem Verteidiger am 18.04.1969 im Berliner Landgericht. Kurras war 1967 von dem Vorwurf der fahrlässigen Tötung des Studenten Benno...
6858388

26.04.1960 - Der zurückgetretene Bundesminister Prof. Theodor Oberländer (l) und der CDU/CSU-Fraktionsvorsitzende Dr. Heinrich Krone am 26.04.1960 zu Beginn der CDU-Vorstandssitzung in Karlsruh...
7142770

07.11.2005 - Anette Orelleno (l), Fachtierärztin für Lebensmittel am Niedersächsischen Landesamt für Verbraucherschutz und Lebensmittelsicherheit (LAVES) in Oldenburg, nimmt am Montag (07.11.20...
7672797

20.03.1986 - Die Angeklagten Hans Friderichs (4.v.l.) und Eberhard von Brauchitsch (r) mit ihren Anwälten auf dem Weg ins Gericht am 20.03.1986, dem 50. Verhandlungstag. Der Parteispenden-Proze...
9500560

23.10.1984 - Reiner Pfeiffer (r) vor dem Untersuchungsausschuss in Kiel am 23.10.1987, umringt von Journalisten. Am Vormittag des 23.10.1984 hat vor dem Kieler Untersuchungsausschuss unter dem...
9752673

27.05.1993 - Der bayerische Ministerpräsident Max Streibl erklärt am 27.05.1993 im bayerischen Landtag in München seinen Rücktritt. Streibl war als Nachfolger von Franz Josef Strauß von 1988 bi...
9752783

27.05.1993 - Der bayerische Ministerpräsident Max Streibl (stehend) am 27.05.1993 im bayerischen Landtag in München. Streibl erklärte an diesem Tag seinen Rücktritt. Streibl war als Nachfolger...
9752807

28.08.2007 - Gänse laufen am Dienstag (28.08.2007) in Wertingen (Schwaben) vor dem Gelände der Firma "Wertfleisch". In der vergangenen Woche wurden hier rund elf Tonnen Gammelfleisch, das nicht...
10516199

28.08.2007 - Hinter einem Vorfahrtsschild steht am Dienstag (28.08.2007) in Wertingen (Schwaben) das verlassene Gebäude der Firma "Wertfleisch". In der vergangenen Woche wurden hier rund elf To...
10516282

24.03.1966 - Offiziere der Bundesluftwaffe verfolgen von der Zuschauertribüne aus am 24.03.1966 im Deutschen Bundestag in Bonn die Starfighter-Debatte. Zwei große Anfragen der Koalition und de...
13214594

10.11.1988 - Zu einem Eklat kam es am 10.11.1988 im Deutschen Bundestag in Bonn während der Rede von Bundestagspräsident Philipp Jenninger zum 50. Jahrestag der NS-Progrome. Abgeordnete der SPD...
13286254

31.07.2011 - Schriftzug EHEC in einer Petrischale und Spritze, Suche nach Auslöser und Gegenmittel des EHEC-Erregers
26168199

17.02.2011 - Ausgewählte Literaturpassagen zu den Plagiatsvorwürfen, Hochformat 135 x 150 mm, Grafik: S. Stein, Redaktion: C. Elmer (AKTUALISIERUNG: Einfügen der Fußnote in den Guttenberg-Teil)
23142970

01.01.2000 - GIB MICH DIE KIRSCHE! - DIE 1. DEUTSCHE FUßBALLROLLE?Gib mich die Kirsche!?D 2006?Oliver Gieth, Peter Hüls?Image: Bild-Zeitung mit der Schlagzeile über den großen Bundesliga-Skanda...
8596932

12.04.2003 - Norbert NIGBUR, Deutschland, Fussball, Torwart, FC Schalke 04,in Zivil, schwoert Eid am Amtsgericht Gelsenkirchen, Bundesligaskandal, Bestechungsskandal im Fussball; SW-Aufnahme;...
10869320

22.07.2017 - Die deutsche Autoindustrie unter Kartellverdacht: offenbar haben sich VW, Audi, Porsche, BMW und Daimler in geheimen Arbeitskreisen abgesprochen und so die Basis fuer den Dieselsk...
92692640

07.04.2010 - Zwei Plakate sind am Mittwoch (07.04.2010) in Biberach aufgestellt: Die Initiative «Ein Mahnmal für die Millionen Opfer der Kirche» prangert auf dem einen Plakat (l) am Biberacher...
18249775

27.07.2010 - Die Odenwaldschule (ODS) in Ober Hambach bei Heppenheim in Hessen, aufgenommen am Dienstag (27.07.2010). Nach den vielen Mißbrauchsfällen hat das Lehrinstitut jetzt Hilfe für die O...
19840287

23.02.2011 - Bundesverteidigungsminister Karl-Theodor zu Guttenberg (CSU) am Mittwoch (23.02.2011) im Deutschen Bundestag in Berlin. Der Politiker, der wegen Plagiatsvorwürfe im Rahmen seiner D...
23244344

05.03.2011 - Demonstranten halten am Samstag (05.03.2011) am Pariser Platz in Berlin bei einer satirischen "Pro-Guttenberg" Demonstration Schilder mit Sprüchen für Guttenberg. Dem Aufruf der Gr...
23411874

23.05.2011 - Eine Mitarbeiterin des Hamburger Instituts für Hygiene und Umwelt hält am Montag (23.05.2011) eine Petrischale mit einem speziellen Nährboden, auf dem EHEC-Bakterienstämme zu sehen...
24763695

23.05.2011 - Ein EHEC-Toxin-Suchtest (oben) und Materialien, die zum EHEC Nachweis benötigt werden, aufgenommen am Montag (23.05.2011) im Landesgesundheitsamt in Hannover. Die Farbe gelb zeigt...
24764168
30.05.2011 - Im Hauptlabor des Landesamtes für Landwirtschaft, Lebensmittelsicherheit und Fischerei Mecklenburg-Vorpommern (LALLF) in Rostock untersucht Patricia Becker am Montag (30.05.2011) a...
24934255

20.09.2011 - Ein Kameramann filmt am Dienstag (10.09.2011) im Deutschen Filmhaus in Wiesbaden das Plakat zum Film "Die Sünderin" (1950) mit Hildegard Knef ab. Das Deutsche Filmhaus in Wiesbaden...
27001110

04.01.2011 - Mit hochgehaltenen Schuhen stehen Demonstranten am Samstag (07.01.2012) vor Schloss Bellevue in Berlin, dem Amtssitz von Bundespräsident Christian Wulff. Dieser steht wegen der Kre...
28892913

17.02.2012 - Bundespräsident Christian Wulff und seine Frau Bettina verlassen am Freitag (17.02.2012) im Schloss Bellevue die Pressekonferenz. Wulff erklärte seinen Rücktritt. Der Bundespräside...
29656483

17.02.2012 - A picture dated February 17, 2012 shows German President Christian Wulff during a press conference at Bellevue Palace, in Berlin, Germany. Christian Wulff announced his resignation...
29666539

15.02.2013 - ILLUSTRATION - Im Landeslabor in Neumünster (Schleswig-Holstein) wird am 15.02.2013 eine Frikadelle vor die Kamera gehalten. Es soll hier untersucht werden, ob sich möglicherweise...
37240775

15.02.2013 - Ein Mitarbeiter zeigt am 15.02.2013 im Landeslabor Berlin-Brandenburg in Berlin die Auswertung einer Analyse auf Pferdefleisch. Nachdem in mehreren europäischen Ländern Rinderhack...
37240953

14.02.2013 - ILLUSTRATION: Eine fast aufgegessene «Gut & Günstig Lasagne Bolognese» von Edeka, aufgenommen am 14.02.2013 in Frankfurt (Oder) (Brandenburg). Auch die Einzelhandelskette Edeka ist...
37325929
18.02.2013 - Eine Probe aus einem Fertiggericht untersucht Ilona Büchner am 18.02.2013 im Labor des Landesamtes für Lebensmittelsicherheit in Rostock (Mecklenburg-Vorpommern) auf Pferdefleisch....
37322577

20.02.2013 - Der nordrhein-westfälische Verbraucherschutzminister Johannes Remmel (Grüne) schaut sich am 20.02.2013 im Chemischen und Veterinäruntersuchungsamt Rhein-Ruhr-Wupper in Krefeld (Nor...
37414688

18.08.1988 - ARCHIV - Dieter Degowski bedroht am 18.08.1988 in Köln die Geisel Silke Bischoff mit einer Waffe. Hans-Jürgen Rösner und Dieter Degowski hatten am 16.08.1988 in Gladbeck-Rentfort e...
41600494

17.08.1988 - ARCHIV - Der Entführer Dieter Degowski bedroht die Geisel Silke Bischoff am 17.08.1988 an der Raststelle Grundbergsee mit einer Waffe. Mit seinem Komplizen Hans-Jürgen Rösner hatte...
41600509

29.08.2013 - Der Limburger Bischof Franz-Peter Tebartz-van Elst segnet am 29.08.2013 die Räumlichkeiten einer Kinder-Krabbelstube in Frankfurt am Main (Hessen). Ausgehend vom Bistum Frankfurt w...
42142703

13.10.2013 - Unbekannte haben am 13.10.2013 auf die Stufe gegenüber der Kapelle des Bischofshauses auf dem Areal der alten Vikarie vor dem Limburger Dom in Limburg an der Lahn (Hessen) eine Kar...
43317166

18.12.2014 - Der frühere SPD-Bundestagsabgeordnete Sebastian Edathy kommt am 18.12.2014 zur Bundespressekonferenz in Berlin, um vor seiner seiner Aussage im Untersuchungsausschuss des Bundestag...
54431633

08.04.2016 - Der Schauspieler Max Mauff hält am 08.04.2016 in Marl (Nordrhein-Westfalen) vor der Verleihung der Grimmepreise eine Plakat mit der Aufschrift «Vermisst», das auf die Abwesenheit d...
67314802

09.09.2016 - Der Satiriker und Moderator Jan Böhmermann, der im März 2016 auf ZDFneo eine umstrittene «Schmähkritik» an Präsident Recep Tayyip Erdogan vortrug, ist als Videoeinspiel bei der ers...
83602666

02.08.2017 - Greenpeace-Aktivisten protestieren am 02.08.2017 in Berlin vor dem Bundesverkehrsministerium mit einem Transparent mit der Aufschrift "Euer Dieselkartell macht uns krank!". Hier fi...
93092038

02.08.2017 - Ein Demonstrant hat am 02.08.2017 in Berlin während einer Aktion vor dem im Bundesverkehrsministerium anstehenden «Diesel-Gipfel» ein Plakat mit der Aufschrift «Euer Diesel ist der...
93099712

04.08.2017 - Ein Mitarbeiter vom Chemischen Veterinäruntersuchungsamt Münsterland-Emscher-Lippe verquirlt am 04.08.2017 in Münster (Nordrhein-Westfalen) eine aufgeschlagene Eimasse. Das Chemisc...
93214954

04.08.2017 - Eine Mitarbeiterin vom Chemischen Veterinäruntersuchungsamt Münsterland-Emscher-Lippe nimmt am 04.08.2017 in Münster (Nordrhein-Westfalen) eine aufgeschlagene Eimasse in Augenschei...
93224946

12.04.2018 - 12.04.2018, Berlin: Die Rapper Kollegah (l) und Farid Bang feiern auf der Party nach der 27. Verleihung des Deutschen Musikpreises Echo. Foto: Jens Kalaene/dpa-Zentralbild/dpa
101543459

29.08.1985 - Der Angeklagte Eberhard von Brauchitsch (r) umringt von Pressevertretern beim Verlassen des Gerichtsgebäudes in Bonn am 29.08.1985. Der erste Verhandlungstag im Bonner Parteispende...
20486045

02.11.1962 - In München demonstrierten am 02.11.1962 Studenten gegen die jüngsten Polizei-Maßnahmen in der Hamburger "Spiegel"-Redaktion. Etwa 300 Teilnehmer maschierten mit Spruchtafeln von de...
27510555

22.07.1960 - Bundesverteidigungsminister Franz Josef Strauß (CSU) überreicht dem Inspekteur der Bundesluftwaffe, Generalleutnant Josef Kammhuber, das Modell eines Starfighters als Erinnerung da...
48797702

22.07.1960 - Bundesverteidigungsminister Franz Josef Strauß (CSU, M) gratuliert am 22.07.1960 auf dem Fliegerhorst in Nörvenich dem Lockheed-Piloten Robert Folkner (l) nach einem Testflug mit...
48925842

30.07.1987 - Der schleswig-holsteinische Ministerpräsident Uwe Barschel (CDU) nimmt am 30.07.1987 auf einer Pressekonferenz in Mölln zu seinem mysteriösen Flugzeugabsturz Stellung. Eine Charter...
50166009

18.05.2016 - Teile von Boehmermanns Schmaehgedicht verboten,titelt die Zeitung Express in Koeln am 18.05.2016. Der tuerkische Praesident Recep Tayyip Erdogan geht juristisch gegen den Satirike...
81893797

18.09.1987 - Uwe Barschel weist bei einer Pressekonferenz mit einem "Ehrenwort" alle Beschuldigungen zurück. Der frühere schleswig-holsteinische Ministerpräsident Uwe Barschel (CDU) wird nach d...
2611213

10.11.1998 - Philipp Jenninger (CDU) nach seiner Rede zum 50. Jahrestag der Reichspogromnacht am 10. November 1988 im Deutschen Bundestag. Rechts die sichtlich erschütterte Schauspielerin Ida E...
2305534

14.08.1988 - Ein Polizeifahrzeug steht vor einem Gehöft, dessen Kälber mit den Hormonen behandelt worden sein sollen, aufgenommen am 14. August 1988. Im Zusammenhang mit dem Kälbermast-Skandal...
2023151

18.03.1966 - Die Trümmer der abgestürzten Maschine auf einer Wiese bei Klosterlechfeld. Ein Starfighter des Jagdbombergeschwaders 32 der Luftwaffe ist am 18.03.1966 kurz nach dem Start abgestür...
7227337

29.08.1985 - "Enteignet Flick" oder "Wer läßt Gangstern schon die Tatwaffe" steht auf Transparenten von Demonstranten, die am 29.08.1985 vor dem Gerichtsgebäude in Bonn protestieren. Im Bonner...
9781079

08.01.1963 - Der Herausgeber des Nachrichtenmagazins "Der Spiegel", Rudolf Augstein (M), wird von zwei Polizeibeamten aus dem Gebäude des Bundesgerichtshofes in Karlsruhe geleitet. Der Dritte S...
2410175

14.08.1988 - Polizeibeamte und Journalisten vor dem Gebäude der Firma Bewital in Oeding/Südlohn, aufgenommen am 14. August 1988. Im Zusammenhang mit dem Kälbermast-Skandal in Nordrhein-Westfale...
2023148

17.08.1988 - Der Entführer Hans-Jürgen Rösner beantwortet am 17.8.1988 mit einer Pistole in der Hand Fragen von Journalisten. Mit seinem Komplizen Dieter Degowski hatte er am 16.8. in Gladbeck-...
2308399

10.11.1988 - Bundestagspräsident Philipp Jenninger (CDU) während seiner Rede zum 50. Jahrestag der Reichpogromnacht am 10. November 1988 im Deutschen Bundestag. Die Rede löste einen Eklat aus u...
2305528

18.09.1987 - Der schleswig-holsteinische Ministerpräsident Uwe Barschel (CDU) weist auf einer Pressekonferenz am 18.9.1987 in Kiel die von seinem ehemaligen Referenten Reiner Pfeiffer erhobenen...
2374069

30.10.1962 - Gegen die Verhaftung von "Spiegel" - Redakteuren demonstriert am 30. Oktober 1962 eine Gruppe von Studenten vor der Frankfurter Hauptwache mit einem Sitzstreik. Der am 8. Oktober 1...
2530198
Haben Sie noch nicht gefunden, was Sie suchen? Registrieren oder melden Sie sich an, um Zugriff auf eine größere Auswahl an Bildern zu erhalten und unser volles Angebot an Bildern, Videos und Grafiken zu nutzen.
Sie haben Fragen?
Haben Sie Fragen oder wünschen individuelle Beratung? Unser Team ist jederzeit für Sie da.
Verkauf / Lizenzierung
Bei Fragen rund um das Thema Lizenzierung








